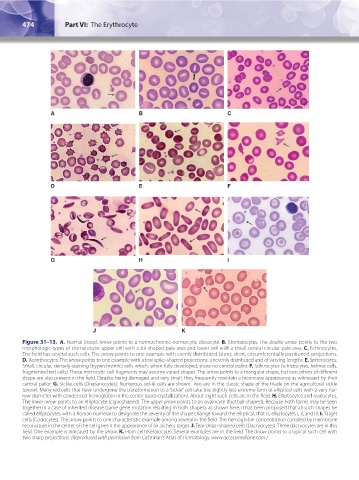

Page 499 - Williams Hematology ( PDFDrive )
P. 499
474 Part VI: The Erythrocyte Chapter 31: Structure and Composition of the Erythrocyte 475
A B C
D E F
G H I
J K
Figure 31–13. A. Normal blood. Arrow points to a normochromic-normocytic discocyte. B. Stomatocytes. The double arrow points to the two
morphologic types of stomatocyte: upper cell with a slit-shaped pale area and lower cell with a small central circular pale area. C. Echinocytes.
The field has several such cells. The arrow points to one example with evenly distributed, blunt, short, circumferentially positioned, projections.
D. Acanthocytes. The arrow points to one example with a few spike-shaped projections, unevenly distributed and of varying lengths. E. Spherocytes.
Small, circular, densely-staining (hyperchromic) cells which, when fully developed, show no central pallor. F. Schizocytes (schistocytes, helmet cells,
fragmented red cells). These microcytic cell fragments may assume varied shapes. The arrow points to a triangular shape, but two others of different
shape are also present in the field. Despite being damaged and very small, they frequently maintain a biconcave appearance as witnessed by their
central pallor. G. Sickle cells (Drepanocytes). Numerous sickle cells are shown. Two are in the classic shape of the blade on the agricultural sickle
(arrow). Many red cells that have undergone the transformation to a “sickle” cell take the slightly less extreme form of elliptical cells with a very nar-
row diameter with condensed hemoglobin in the center (para-crystallization). About eight such cells are in the field. H. Elliptocytes and ovalocytes.
The lower arrow points to an elliptocyte (cigar-shaped). The upper arrow points to an ovalocyte (football-shaped). Because both forms may be seen
together in a case of inherited disease (same gene mutation resulting in both shapes), as shown here, it has been proposed that all such shapes be
called elliptocytes with a Roman numeral to designate the severity of the shape change toward the elliptical, that is, elliptocytes I, II, and III. I. Target
cells (Codocytes). The arrow points to one characteristic example among several in the field. The hemoglobin concentration corralled by membrane
recurvature in the center of the cell gives it the appearance of an archery target. J. Tear-drop–shaped cells (Dacryocytes). Three dacryocytes are in this
field. One example is indicated by the arrow. K. Horn cell (Keratocyte). Several examples are in the field. The arrow points to a typical such cell with
two sharp projections. (Reproduced with permission from Lichtman’s Atlas of Hematology, www.accessmedicine.com.)
Kaushansky_chapter 31_p0459-0478.indd 474 9/18/15 10:59 PM